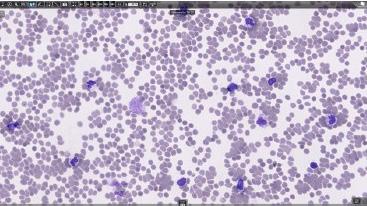

March 2026
Sysmex Connect

In this issue
IBMS Congress 2025
Sysmex UK User Symposium 2025
Training Academy – New courses now available
Perfectly orchestrated clinical flow cytometry solutions



Note from the Editor
Welcome to the March 2026 edition of Sysmex Connect. This issue offers the latest developments, stories, innovations and highlights from Sysmex UK and the wider diagnostics community.
We revisit our major events of 2025, including a review of the IBMS Congress, where our new XF-1600 with 14 - colour capability made its first UK appearance, and a look back at our hugely successful Sysmex UK User Symposium 2025, attended by more than 200 delegates. We share some wonderful customer feedback, star- ratings and event statistics which capture the strength of the scientific programme, venue experience, and quality of interaction throughout the two-day event. The planning of this year’s User Symposium has commenced, save the date in your diary! and have a look at the details for the poster competition including the £3,000 educational grant.
Continue to read on where we introduce several new Training Academy courses including expanded CN -Series learning pathways, webinar series updates, support on improved navigation for users, and the upcoming launch of the enhanced RAL Stainer Routine Use Training course. This issue also features deep dives into clinical flow cytometry, haemostasis innovation, and the latest digital morphology database management best practices.
On page 28, we share a customer testimonial on the successful multi-site XR-Series installation. Take a look at our powerful Pannoramic MIDI III scanner for high - quality brightfield and fluorescence imaging on page 30 and 31. There is also an update from the recent CellWiki Quiz, celebrating participants and championing continuous learning across laboratories.
We highlight new ways for customers to connect with Sysmex UK through enhanced Customer Support Centre services, including WhatsApp support and a real-time Live Chat function via Caresphere Academy.
Our sustainability pages share progress on the Sysmex Eco -Vision 2033 goals, and ongoing initiatives supporting carbon reduction, and responsible resource use.
Towards the end of the newsletter, we close on two research summaries in our Growing Your Knowledge section, exploring the diagnostic value of Sysmex Cell Population Data in suspected sepsis and new neonatal CBC reference ranges.
We hope this issue provides you with valuable knowledge, practical insights, and inspiration as we continue working together to advance diagnostics and support better healthcare journeys. As always, we welcome your feedback and topic suggestions at marketing@sysmex.co.uk
Sysmex Connect Editorial Team

Sysmex Remember to connect with us on LinkedIn.
IBMS Congress 2025 Driving innovation in diagnostics

We are thrilled to share highlights from our successful participation at IBMS Congress, which took place from 22nd – 25th September 2025, at The International Convention Centre (ICC) in Birmingham.
The event brought together leading professionals in the biomedical science community including biomedical scientists, lab managers, healthcare professionals, key decision makers and influencers in the field.
Sysmex UK was proud to be a Principal Sponsor, and were delighted to connect with so many professionals, share insights, and explore opportunities for collaboration.
Our stand featured a fresh, clinical design and showcased our Point of Care (POC) offering, the
CN-6500, and the exciting launch of the XF-1600 with 14-colour capability. IBMS Congress was the very first external platform in the UK where we demonstrated the 14-colour device and its latest advancements. This milestone marked a significant advancement for our Flow Cytometry offering and the future of flow cytometry solutions in laboratory diagnostics.
To create a welcoming and engaging environment for all our visitors, we included a Sysmex branded coffee bar with a professional barista serving freshly prepared Sysmex branded beverages throughout the event - a real crowd-pleaser! We also had a seating area on the stand to support continuing conversations in our relaxed setting.









Thank you to everyone who visited our stand. We look forward to continuing the conversations, and working together to deliver innovative solutions for the biomedical science community.
Sysmex UK User Symposium 2025
On 18th – 19th November 2025, Sysmex UK hosted its highly anticipated User Symposium at the prestigious Midland Hotel in the heart of Manchester.
This two-day event included an outstanding scientific programme, featuring thoughtprovoking sessions led by Key Opinion Leaders, expert speakers, and experienced chairs.
There were 215 delegates in attendance, the event was a great opportunity to share knowledge, network and collaborate with our customers and all professionals within the scientific community.
A highlight of the symposium was the Gala Dinner on Tuesday evening, where our delegates enjoyed an evening of fine dining and live entertainment, creating the perfect setting for further interactions and celebration.





Sysmex updates
Sysmex staff delivered two fantastic Sysmex update presentations that were included on day 2 of the scientific programme:


Training Update - XR-Series
Comprehensive Course Review
Nikita Jacob
Training Specialist, Sysmex UK
The Practical Benefits of Monocytosis Workflow Optimisation
Aimee Guiste
Haematology Application Specialist, Sysmex UK
"This two-day event included an outstanding scientific programme, featuring thought-provoking sessions."
What did our attendees say about SUK User Symposium 2025?
Event Experience
“ Very well organised event, I felt well taken care of and benefitted greatly from the programme. Keep up the good work!”
“All very good and very well organised and Sysmex reps were lovely.”
“ The whole event was really well organised. There was a good range of topics and ALL speakers were engaging. Really liked the little touches like making lunch on day 2 a grab-and-go pack for us travelling home!”
“A great event. Keep up the good work.”
“Well organised and structured event with a variety of presentations.”
“It was a great event that was thoughtfully organised.”
“A fantastic event all round. Thank you to Sysmex for another great symposium.”

“Quality of the speakers and topics. Great variety of topics covered. Gala dinner was excellent as always and being able to see Sysmex staff was great.”











What did our attendees say about SUK User Symposium 2025?
Venue & Hospitality
“Hotel, food and organisation were fantastic, thanks to everyone who made it all happen. A very enjoyable symposium as always.”
“Interesting talks, great social aspect and excellent venue.”
“Well organised. Fantastic venue.”
“I have been attending the User Symposiums for many years, and the Sysmex Family have always looked after us providing appropriate scientific content and social downtime that helps to bring a little joy to our busy and often changing working lives - keep up the good work and thank you for the invite.”
“The venue, food and company were fantastic as always.”


















Event statistics
215
Delegates
18
Poster submissions
5
Poster winner Chairpersons Conference room
16
Speakers
1
4
Poster judges Day programme
1
2
Customer survey results
Attendees were asked to rate elements of the SUK User Symposium 2025: 1 Star = Very difficult - 5 Star= Excellent.
& communication
update presentations
Sysmex UK would like to take this opportunity to thank everyone who joined us and made this event such a success! Your continued support and dedication to the annual User Symposium are truly valued. We look forward to welcoming you again in November 2026!
SAVE THE DATE
Sysmex UK User Symposium
24TH - 25TH NOVEMBER 2026
THE MIDLAND HOTEL, MANCHESTER

Sysmex UK are thrilled to invite you back to our flagship annual User Symposium. Across two engaging days, you will experience a series of insightful presentations from leading industry experts and Key Opinion Leaders, showcasing the latest innovations and advancements in pathology and laboratory diagnostics.
Location
The Midland Hotel, Manchester, UK
The venue is conveniently located for visitors travelling to Manchester.
The Midland Hotel is surrounded by excellent transport links, and is easy to reach whether travelling by road, rail or by plane.
Topics
■ Haematology
■ Haemostasis
■ Clinical Flow Cytometry
■ Sustainability
■ User experiences
■ Clinical advancements
■ Research presentations
■ Case studies and much more!
Sysmex UK User Symposium 2026
- Call for posters
Sysmex UK Scientist Award - Poster Competition
We’re looking for your posters!
Submit your work for the Sysmex UK Scientist Award Poster Competition at the 2026 Sysmex UK User Symposium. Each year, the quality of submissions from our customers is exceptional, and we can’t wait to see yours!
Ask yourself:
■ Are you a BMS Grade 6 or below?
■ Are you working on a project that would benefit from a poster presentation?
■ Do you want the right audience to showcase your findings?
If you answered YES to all of the above, this competition is for you!


Benefits for poster authors:
■ Free entry to Sysmex UK User Symposium 2026
■ Your poster will be displayed throughout the event
■ Gain exposure to BMS and pathology community
■ Posters being reviewed by a panel of Poster judges / Key Opinion Leaders
■ Winner to receive an educational grant worth £3,000 to support further studies and CPD recognition.
What we need from you:
■ Full Name
■ Job Title
■ Hospital Site
■ Email Address
■ Band level
Entry requirements:
■ The Poster must be submitted before:
Friday 30th October 2026
■ Design size: A0 in portrait layout
■ Submit in PDF format
■ Include an abstract in a Microsoft Word document (max 500 words)
Note:
Posters from BMS above Grade 6 are welcome but will not be eligible for the competition.

Sysmex UK User Symposium 2025










Tips on creating a winning scientific poster
Content & Structure
How did you decide what information was essential versus what could be left out?
■ I focused on the core research question, key methods, and the most important findings. If a piece of information did not directly support the main takeaway, I either summarised it in one sentence or removed it. The key take away box concluded what had been presented in the entire poster. I treated the poster as a visual abstract rather than a full paper, to provide clarity, with the QR code with the full paper should any one want to read further.
What strategies did you use to make complex data easy to understand for the audience?
■ I simplified graphs and avoided unnecessary statistical details on the poster itself. Instead of dense tables, I used clear figures with concise captions. When possible, I replaced technical explanations with short, plain-language summaries.
How did you balance text with visuals so the poster did not feel cluttered?
■ I aimed for roughly 40–50% visuals and 50–60% text. I limited paragraphs to short bullet points and ensured every visual had a purpose and if it did not clarify something, I removed it.
Design & Visual Impact
What were your go-to principles for colour schemes and font choices?
■ I used a simple colour palette (2–3 complementary colours) and avoided overly bright combinations. I chose Arial font for readability. Headings were bold and larger, while body text remained consistent and simple.
How did you ensure your poster was readable from a distance?
■ I ensured that headings were readable from 1–2 meters away. I used large font sizes typically 72+ pt for titles, 36–44 pt for headings, 24–32 pt for body text and ensured strong contrast between text and background.
Did you use any tools or templates for layout design? If so, which ones?
■ I used Microsoft PowerPoint for layout flexibility and easy formatting.
Engagement & Accessibility
How did you make your poster appealing to the audience?
■ I made the title clear and compelling, highlighting the practical significance of the study. I also used visuals strategically to draw attention to key findings. Clear lay out and section headings helped guide the reader’s eye naturally from introduction to conclusion.
What made you include interactive elements / CTAs (call to action) in your design?
■ I included a QR code linking to the full paper or contact information. This allowed interested viewers to explore further without overcrowding the poster. It also encouraged follow-up conversations beyond the session.
How did you ensure your poster was accessible for people with visual impairments (i.e. colour, contrast)?
■ I used high contrast between text and background and ensured graphs did not rely solely on colour to convey meaning, and included a table to easily distinguish sensitivity and specificity.
Practical Tips
What common mistakes should future poster authors avoid when creating posters?
■ Overloading the poster with text
■ Using font sizes that are too small
■ Include too many colours
■ Presenting raw data without interpretation
■ Ignoring alignment and spacing
■ Waiting until the last minute to design and print
How much time did you typically spend on your poster?
■ I spent 1–2 weeks in total. The first few days were dedicated to selecting and refining content. The remaining time focused on layout, revisions, feedback from colleagues, and final formatting adjustments before printing.

Training Academy

We've upgraded our course catalogue - here's what's new!
Introducing “Catalogue”
Our course catalogue, previously known as the "Storefront" has been renamed to "Catalogue", denoted by a book icon. We feel this better represents our full range of courses, webinars, and resources.
Our search bar feature remains. Here, you can search for your intended course or webinar using keywords, or by selecting the tiles below to choose trainings based on their discipline or content. Want to search for all our courses? Click in the search bar and press enter!
Our carousel displays our newest courses and webinars. Simply click 'Learn more' for more detail and to enrol.

This banner will showcase interesting topics or courses, connecting with the carousel below. The carousel will display relevant courses to our chosen monthly topic, or remind you of any valuable courses you may not have come across.



Here, we have presented our most popular courses by discipline for inspiration. Remember, you can find all courses and webinars filtered by discipline using the search bar feature.
New courses
Haemostasis
CN-Series: Haemostasis principles of analysis
Our new, self-paced course is designed to guide you through the key analytical principles and best practices needed to ensure accurate and reliable laboratory results. This interactive course replaces our existing CN-Series Principles of Analysis Interactive Webinar Recording.
The course provides a comprehensive understanding of the optical and analytical principles behind the CN-Series instruments. It explores how light is transmitted through samples and how the system utilises multiple wavelengths to analyse and interpret results across various assay types. The modules also cover sample and reagent handling, from transport and processing to proper storage practices. Special attention is given to the detection systems, interference analysis, and the operation of micro and normal sample modes. Finally, you will learn to recognise and interpret common multi-wavelength errors and gain-switching analysis to ensure reliable results.
Click the button below to find the new course in our CN-Series Measurement Principles Learning Path within the CN-Series Learning Path.
> CN-Series Learning Path

Full power of platelet aggregation testing
We’re excited to announce the launch of our brand-new course Full power of platelet aggregation testing designed to help you unlock the full potential of platelet aggregation testing with the CN-Series. This interactive course explores the science, workflow, and advanced functionalities behind platelet aggregation testing in a fully interactive format.
The course summarises the basic principles of primary haemostasis and light transmission aggregometry (LTA), explains how to apply the correct procedures for preparing and handling samples for platelet aggregation testing, and allows users to confidently operate the Sysmex LTA application to perform measurements accurately. Users will also develop the skills to interpret test results reliably, identify unusual or unexpected findings, and take appropriate steps for troubleshooting or seeking expert advice when required. Gain practical knowledge and confidence to perform platelet aggregation assays with the CN-Series.
Click the button below to access the Full power of platelet aggregation testing via our CN-Series Learning Path.
> CN-Series Learning Path


Diagnostics in Practice: A laboratory webinar series
Join us for a new quarterly webinar series, diving into real-life case studies and specialist insights on using Sysmex solutions to tackle everything from haematological malignancies to platelet management — all designed to make your lab life easier and your diagnostic processes more effective.
In webinar 1, we looked at how our Sysmex products in Haematology and Flow Cytometry disciplines can help laboratories deliver accurate, efficient diagnostic results for patients with haematological malignancies. We applied this knowledge to webinar 2, where we dived into two interesting case studies. Webinar 3 will focus on how Sysmex solutions can enhance platelet management, demonstrating practical applications and the benefits they offer in the laboratory. Finally, webinar 4 will apply this knowledge to some interesting case studies surrounding platelet disorders.
The first two webinars have already taken place, but the recordings are available to watch by cliking the button below.

Keep an eye on Caresphere Academy for upcoming announcements about Webinar 3!

Haematology
XN-Series Learning Path
The XN-Series learning path brings together all XN related material in one place! Not only does it have content for practical use of the analyser, it also brings together analyser theory, haematology fundamentals and other supplementary courses. The learning path allows the user to select the courses they need, from an easy to navigate list, whilst linking previous training history and certificates. Click the button below to enroll on the XN-Series learning path.

New courses

Brand new RAL® Stainer Routine Use Training Course
After months of development, we’re excited to finally share what’s coming next! Our brand-new, enhanced RAL® Stainer Routine Use Training course is launching soon. Designed to align seamlessly with our popular training portfolio, this updated course is packed with engaging interactive content, videos, and knowledge checks to guide you through every aspect of daily RAL® Stainer use. Plus, a dedicated troubleshooting section will help you confidently identify and resolve some of the most common instrument issues - so you can keep your workflow running smoothly.



General interest
Social Values Learning Path
Social values are defined as the positive impact that actions can have on people and society. The Social Values learning path looks at some of these key areas, such as sustainability, diversity and health and wellbeing and how each of these can be developed to improve and strengthen communities. The learning path aims to inform users about these important topics and provide a foundation for how social value can be carried out by all of us.
Click the button below to enroll on the Social Values learning path.
> Enrol here







www.sysmex.co.uk
Perfectly orchestrated clinical flow cytometry
What makes a great orchestra? To perform the widest possible repertoire of pieces of music, a large variety of instruments is of the essence. Skilful players and instruments of the finest quality make for an excellent sound, aided by the brilliant acoustics of the concert hall. Last but not least, the conductor brings all this talent to life, to the enjoyment of the audience.
Imagine you are a conductor, with a range of high-quality devices demonstrating a perfect interplay in your clinical flow cytometry lab. With this perfectly orchestrated setup - from instruments to reagents to necessary information - you can attend to each sample coming in for analysis with the most relevant tests in a timely manner, streamlining the diagnostic workflow. Raise the baton - may the concert begin!
■ Perfectly orchestrated order assessment: with all haematology results and cell images ona single screen of the CyFlow WA middleware, you can assess the open orders for clinical flow cytometry and confer with the clinicians whether orders should be extended or modified up front - every hour may count for the patients.
■ Perfectly orchestrated panel creation: the comprehensive CyFlow™ CE-IVD antibody portfolio offers an abundance of analytical possibilities, swiftly configured on the PS-10 sample preparation system and brought to light in the XF-1600 flCNV cytometer.
■ Perfectly orchestrated sample preparation: the PS-10 sample preparation system autoadapts dilutions for each sample according to the WBC count received via the CyFlow WA middleware.
■ Perfectly orchestrated sample handllng: a bar-coded sample tube carrier, the rotor, is used across all devices, from the sample preparation system PS-10 via the wash centrifuge Rotolavit 11-Sto the flow cytometer XF-1600, including automated transfer of each rotor's worklist. This makes sample tube handling safe and easy, and the whole workflCNV more efficient.
■ Perfectly orchestrated result valldatlon: the CyFlow WA middleware displays all clinical flow cytometry results along with the haematology results on one screen, for best possible result validation to the benefit of the clinicians and the patient behind.
For more details or to speak with the Flow Cytometry team, please email: FlowCytometry@sysmex.co.uk
Haemostasis in focus: What's new?
Novel High-Sensitivity Chemiluminescent (HISCL) Technology integrated into routine CN-3500/CN-6500 coagulation analysers
Back in April 2025, we shared the exciting news that the HISCL HIT IgG Assay Kit had achieved UKCA regulatory approval intended to aid the diagnosis of heparin-induced thrombocytopenia (HIT) through IgG quantitation. Since then, momentum has been building. Our Sysmex UK Haemostasis Product Team has been out in the field, upgrading CN-3500 and CN-6500 analysers to bring this breakthrough assay to life.
Already, five leading laboratories across the UK are in their verification phase, with two successfully completed, and a further five set to join them in the coming months. The rollout is well underway, and the future of readily available HIT testing is arriving faster than ever.
Straight from the lab: Customer feedback on the first installation/verification
Operator assessment

In May 2025, Richard Kirby, Senior Biomedical Scientist at Nottingham University Hospitals (NUH) NHS Foundation Trust, began verification of the new HISCL HIT IgG Assay Kit. Over the following two months, he carried out a comprehensive series of studies to evaluate the assay’s performance against their existing platforms. These included assessments of inter- and intra-precision, method comparison, calibration with both serum and plasma, measurement of uncertainty, and throughput studies.
Clinical assessment
The NUH data demonstrated excellent inter- and intraprecision (CV <10%) across both low and high controls, confirming the assay’s reliability regardless of concentration. In method comparison studies, the HISCL HIT IgG assay showed markedly improved sensitivity over other automated platforms when benchmarked against patients’ clinical diagnoses and using the manufacturer-derived cut-off of 0.6 U/mL. This enhanced sensitivity may remove the need for a confirmatory ELISA - a step routinely performed in this laboratory - thereby streamlining the workflow, reducing costs, and saving valuable resources. Based on these findings, overall agreement was deemed satisfactory, supporting the adoption of the HISCL HIT IgG Assay Kit as the diagnostic assay of choice.
NUH reported that calibration with the HISCL HIT IgG assay was straightforward and user-friendly, requiring only the dispensing of liquid, ready-to-use calibrator material into sample cups for processing. A 5-point calibration curve, run in duplicate, was completed in just 56 minutes for both plasma and serum specimen types using a single calibrator. Importantly, the coagulometer side of the analyser continued to function without interruption during the process.
Verification studies confirmed excellent linearity and stability across the calibration curve, with a limit of detection of 0.1 U/mL and a measuring range for plasma up to 128.0 U/ mL. Unlike other platforms, recalibration is not required following substrate, wash, or consumable reagent lot changes, only when the reagent itself changes, allowing calibration frequency to be reduced, saving both time and resources. From reagent preparation and loading through to test ordering and result output, the workflow was described as simple and fully aligned with existing coagulometer processes, minimising training needs and avoiding the burden of additional instrumentation for HIT testing.
In real-world use, the shortest time to result was 19 minutes from pressing start on the analyser, closely matching the manufacturer’s claimed 17-minute time (measured from sample aspiration within the HISCL module). For rack runs of six samples, the laboratory achieved an average turnaround time of 25 minutes per sample - significantly faster than other automated platforms, supporting both efficient, timely and accurate clinical decision-making.


Evolving testing paradigm
Disorders involving anti–platelet factor 4 (PF4) antibodies continue to attract significant scientific attention as an evolving field of study. Following the SARS-CoV-2 pandemic and the adoption of adenovirus vector–based vaccines, a new pathology emerged - vaccine-induced thrombotic thrombocytopenia (VITT). VITT shares a similar pathophysiology to heparin-induced thrombocytopenia (HIT), but with a different trigger: vaccination rather than heparin exposure. This created an urgent need for immunoassays capable of detecting IgG antibodies against PF4 in post-vaccination patients presenting with unprovoked thrombocytopenia and thromboses in unusual sites, bringing the versatility of HIT assays sharply into focus.
As research has progressed, additional triggers have been identified that drive the same pathological mechanism - for example, monoclonal gammopathy of thrombotic significance -further reinforcing the clinical demand for assays that can detect anti-PF4 autoantibodies across a range of conditions.
As part of NUH’s verification of the HISCL HIT IgG Assay Kit, the laboratory also evaluated its ability to detect VITT IgG antibodies. The assay demonstrated weak sensitivity - a result
for Thrombosis and Haemostasis (ISTH) 2025 meeting in Washington, DC (see QR code). This outcome mirrors results from other automated HIT platforms, where the presence of heparin within the assay detection principle can competitively bind to the PF4 epitope targeted by VITT antibodies, thereby blocking their binding. Partial sensitivity observed in UK NEQAS EQA samples may be attributable to the way PF4 is coated onto the magnetic particles in the assay design, or to the heparin–PF4 stoichiometry, both of which can influence antibody binding and ultimately affect assay sensitivity to autoantibodies.


Scan the QR code to read more information

The journey doesn’t stop here… discover what’s coming next
At Sysmex, we are committed to driving innovation in our products and services that bring value to the patient, laboratory staff, and clinicians, to support a better healthcare journey. For a sneak peek of our latest innovation in integrated HISCL technology, click the button below to check out this paper published in the Journal of Thrombosis and Haemostasis.
XR-Series installation

Yolande Davies, at the time of the interview was the Haematology Manager at Manchester University NHS Foundation Trust Hospital (MFT). Yolande has recently changed positions, and is now the Blood Transfusion Laboratory Manager at Wythenshawe Hospital.
MFT is one of the largest acute NHS Trusts in the UK, serving a population of approximately 750,000 people across Greater Manchester. There are four laboratory sites in this trust: Oxford Road Campus, Trafford General Hospital, Wythenshawe Hospital and North Manchester General Hospital, collectively processing approximately 6500 full blood count samples a day.
The service operates within a hub-and-spoke model, supporting a wide range of acute and specialist clinical services including oncology, haemophilia, burns, cardiothoracic surgery, infectious diseases, emergency care and GP services.
Customer Experience: Delivering a Multi-Site
XR-Series Installation
This is my first formal interview or testimonial for Sysmex. While I have previously engaged with Sysmex through user meetings and professional discussions, this is the first time I have shared our experience in this format.
In November, I also presented this subject at the Sysmex User Symposium, which was my first time presenting at a Sysmex event. I found it a very enjoyable and rewarding experience. What I particularly appreciated was the opportunity to share our journey on a large UK platform, not just the technical outcomes, but also the lessons learned, challenges faced, and practical insights from delivering a complex, multi-site equipment refresh. My aim was to help other laboratories facing similar pressures.
Why We Decided to Change Instrumentation
The decision to change instrumentation was primarily driven by the age of our existing equipment. Many of our analysers had exceeded their intended lifecycle, with some over 10 years old and one site approaching 14 years of use. While the managed service contract required an equipment refresh, the greater driver was the need to improve reliability, reduce

downtime, and minimise the increasing maintenance burden associated with ageing instrumentation. We also needed to standardise platforms across sites to improve quality, resilience, and future readiness.
Although I have led equipment refresh projects before, this was my first time leading a refresh of this scale across four laboratory sites. The size of the organisation, the geographical spread, infrastructure variation, and the requirement to maintain uninterrupted clinical services made it a very different and significantly more complex undertaking.
Delivering a Multi-Site Installation
Infrastructure proved to be the biggest challenge, particularly power limitations at one site, where it was not possible to safely power both old and new equipment simultaneously to support verification, training, and service continuity. Despite this, the benefits of a multi-site installation were significant. Standardisation across laboratories improved resilience and allowed staff to validate results remotely using EPU when one site was under pressure. Training could be shared across sites rather than being centred in one location. The staggered rollout also meant that lessons learned from early installations could be applied to subsequent sites, reducing risk and disruption.
Working in Partnership with Sysmex
Support from the Sysmex teams was critical to the success of the project. The dedicated installation team brought together engineers, IT specialists, and product experts, which made planning and delivery far more efficient. The project felt very much like a partnership, with co-creation and collaboration at the heart of how we worked together. Decisions, workflows, and adaptations were discussed and agreed jointly, ensuring that solutions were practical and aligned with our operational needs.
The use of a live SmartSheet® tracker provided transparency around progress, actions, and documentation, allowing risks to be identified early and mitigated. Online training resources complemented on-site training and aligned well with local training needs, allowing staff to learn and adapt at a pace that worked alongside service pressures.
Impact of the XR-Series
The XR-Series has significantly improved reliability and reduced downtime across our sites. Standardisation has strengthened resilience and enabled more efficient sample processing, eliminating pinch points even during peak demand. The higher throughput has created capacity headroom for future growth, while automation of maintenance and QC processes has allowed staff to focus on higher-value clinical tasks. Overall, it has supported sustainability, staff development, and service continuity. We have also seen clear benefits from the new WDF Lysercell II reagent. The improved separation of cellular populations, particularly between eosinophils and neutrophils, has been especially valuable for our oncology services. This improved differentiation has reduced the number of blood films requiring manual review, shortened turnaround times, reduced workload pressure, and improved the quality and consistency of results provided to clinical teams.
A “Gold Star” for the BT-50
The BT-50 has been a real asset for our laboratories. The controlled temperature storage of QC material supports QC stability and ensures compliance with manufacturer requirements and regulatory standards, including UKAS expectations for reagent storage. Automating the warming and mixing of QC material has significantly reduced failed QC events associated with manual handling, leading to cost savings through reduced wastage.
In addition, scheduled automated QC and maintenance — particularly overnight — has been transformative for sites that close out of hours. Staff arrive to analysers that are maintained and controlled, ready for immediate use, allowing them to focus on clinical work from the start of the day.
Sysmex Focus

Feedback from the Laboratory Teams
Feedback from the wider laboratory team has been very positive. Staff have highlighted the ease of sample analysis and the reduction in manual processes. Having the same sampling mechanism across the XR analysers and the SP50 slide maker and stainer has streamlined workflows and reduced handling steps. This consistency has also supported the use of false-bottom sample tubes, which has been particularly beneficial for paediatric samples.
As a result, fewer manual blood films are required, reducing hands-on time, improving safety when working with smallvolume samples, and easing workload pressures. Staff have also valued the improved QC performance and the reduction in time spent on routine maintenance.
Project Delivery and Go-Live
Overall, the project was complex and demanding, particularly due to infrastructure constraints such as limited and unstable power at some sites. These challenges were managed through phased installation planning, relocating training where necessary, and close collaboration with Sysmex. The live project tracking and regular communication allowed us to plan around issues, maintain service continuity, and protect patient safety throughout.
The go-live experience was well supported and carefully planned. Sysmex specialists were present on site, staff were prepared and confident, and any issues were addressed promptly. As a result, go-live was smooth despite the complexity of the environment.
Looking Ahead
The XR-Series provides a strong foundation for future development. It supports further automation, enhanced diagnostic capability, digital morphology expansion, and improved integration with digital systems. Most importantly, it strengthens resilience and flexibility, allowing us to adapt to increasing demand and evolving clinical needs while continuing to deliver high-quality patient care.
Reflecting on the project, the biggest lesson for me was that successful equipment refreshes are about people as much as technology. Early engagement, protecting staff wellbeing, strong governance, open communication, and reflective practice were all essential. Flexible, values-based leadership helped us navigate complexity, maintain trust, and deliver a successful outcome without compromising service quality or patient safety.
Brightfield & Fluorescence Slide Scanner
Pannoramic MIDI III

Exceptional Scanning Quality in a Compact Format

Pannoramic MIDI 11
The Pannoramic MIDI Ill is a compact bench-top slide scanner, that sets new standards in image quality and scanning speed.
The Pannoramic MIDI Ill seamlessly integrates brightfield and fluorescent scanning capabilities with a 12-slide capacity, delivering exceptional efficiency for high-quality imaging. Its leading optical system achieves outstanding resolution down to 0.1 o μm/pixel, providing ultra-sharp clarity and enabling the visualisation of even the finest tissue details for accurate and reliable results.
What sets the Pannoramic MIDI Ill apart is its dual-camera system with a motorised camera changer, seamlessly switching between brightfield and fluorescence modes. The MIDI Ill offers 9 filter positions and supports up to 45 fluorescent channels making it ideal for multiplex biomarker analysis and complex fluorescence scanning.
Its automated tissue detection, barcode reading. and optional Z-stack and Extended Focus scanning provide unparalleled functionality, saving time and minimising manual intervention. Compact yet robust. the Pannoramic MIDI Ill stands out with its user-friendly design and low maintenance requirements, offering a powerful. reliable, and cost-effective solution that outperforms conventional scanners in precision, flexibility, and ease of use.
Key Features
✓ Rapid brightfield scanning with advanced LED Flash Scanning Technology
✓ 3 high-quality objectives for maximum flexibility
✓ Dual-camera system for optimised scanning
✓ New multi-channel fast fluorescence pre-scan
✓ FISH analysis capabilities
✓ Comprehensive software package included for slide viewing, management and sharing
Would you like to know more about our solutions? Please get in touch!
Technical Specifications
Slide capacity 12 slides
Objectives 4x (FL only); 20x; 40x
Brightfield scan speed 1 min 30 s (20x, 15 mm x 15 mm)
Fluorescence scan speed 8 min 30 s (20x, 3 FL channels, 20 ms exposure)
Filter positions 9
Multi-Layer-Scanning Z-stack and extended focus with up to 30 focus planes at adjustable intervals
Software Scanner control software, SlideCenter, SlideManager, QuantServer
Dimensions (W x D x H) cm 84 x 55 x 64
Weight(kg) 43,5
CellWiki winners
The recent CellWiki Quiz, hosted in collaboration by Sysmex and CellMasters, delivered an engaging and educational experience for laboratory professionals throughout the world with a shared passion for cell morphology.
Designed to be both challenging and enjoyable, the quiz invited participants to test their knowledge using real-world case scenarios and high-quality images from CellWiki. Questions covered a broad range of topics and difficulty levels, encouraging participants to think critically, refine their diagnostic skills, and build confidence in everyday cell identification.
The event highlighted the shared commitment of Sysmex and CellMasters to supporting ongoing education and professional development within the laboratory community. By combining Sysmex expertise in diagnostic innovation with CellMasters’ focus on morphology training, the CellWiki Quiz offered meaningful value beyond competition—reinforcing best practices and lifelong learning.
Feedback from participants was overwhelmingly positive. Many appreciated the practical relevance of the questions, the clear and accessible format, and the opportunity to benchmark their knowledge in a supportive environment. The quiz also fostered a strong sense of connection, bringing professionals together through a shared learning experience.
The CellWiki Quiz is a great example of how interactive education can strengthen engagement and empower customers. Sysmex and CellMasters remain committed to creating opportunities that help laboratory professionals stay confident, capable, and connected—supporting accurate diagnostics and high-quality patient care every day. We are pleased to recognise the top 20 UK participants in the CellWiki Quiz. Their outstanding performance reflects a high level of expertise, attention to detail, and commitment to excellence in cell morphology. Congratulations to all our UK winners on this fantastic achievement.

Well done to all
and thank you to everyone who took part.
We look forward to welcoming you to future CellWiki learning activities.
Sysmex Customer Support Centre
Sysmex WhatsApp
In today’s omnichannel world, WhatsApp has quickly emerged as the most popular go-to messaging app around the globe. It’s a fast, simple, and convenient way to communicate in real time from ANY location.
You can share photos and videos, send, and receive documents, and engage in secure conversations.
To get started…
■ Simply scan the Sysmex WhatsApp QR code using your mobile phone
■ Begin typing your message to initiate a conversation with our support desk

■ You will be asked some simple questions to ensure you are directed to the correct specialist first time round (i.e. case reference number, serial number and error code if applicable)

Sysmex Live Chat
Benefits
■ Direct connection to a Sysmex specialist
■ Secure and trustworthy (all WhatsApp chats are encrypted)
■ No need to call or email
■ Flexible messaging channel - report issue from any location
■ Ability to share photos, videos and documents for troubleshooting
■ Two-way communication
■ Greater convenience
Access our support services quickly and communicate with us in real-time with our online ‘Live Chat’ service. In just 4 simple steps, you can immediately start speaking to a Sysmex Specialist!
1. Log into Caresphere Academy
2. A pop-up box will appear on the main home screen, simply click “Chat now”
3. Fill out your details, including a brief description of your query
4. Press "Send" to initiate the chat
You will then be connected to a Specialist on our support desk for your chosen discipline.
Benefits
■ Instant connection to a Customer Service Specialist
■ Communicate in real-time
■ Resolve queries faster
■ Greater convenience
■ Instant document or file transfer
■ The conversation can be kept for future reference (we can email a copy to you once the chat has ended if required)
■ Non-intrusive - allows users to multi-task and continue working whilst the Specialist solves the query
■ Reduces repetition – the Specialist has visibility of customer details at the beginning of the chat session (such as serial number, name and hospital site)



Sysmex global sustainability goals
In May 2023, Sysmex formulated “Sysmex Eco-Vision 2033”. This is the long-term environmental vision that the Sysmex Group strives to achieve by 2033, to support the realisation of a circular society. Sysmex has also set new carbon neutral targets, with the aim of achieving zero emissions of greenhouse gases in real terms from the offices of the entire Sysmex Group by 2040 – this applies to direct greenhouse gas emissions under scope 1 and 2.
As part of the “Sysmex Eco-Vision 2033,” Sysmex has set reduction targets for its own GHG (Greenhouse gas) emissions (Scope 1 and 2) and its supply chain GHG emissions (Scope 3). Sysmex Corporation has been approved by the Science Based Targets initiative (SBTi), an international initiative working to overcome the environmental crisis on the basis of climate science, for the Group’s fiscal 2033 greenhouse gas reduction target.

A gold medal performance



In 2025, Sysmex disclosed its environmental, social and governance (ESG) performance actions and processes and had them objectively assessed by EcoVadis, the world's leading provider of corporate sustainability assessments. As a result, Sysmex Europe SE was awarded a gold medal. With its broad commitment to sustainability, Sysmex Europe is among the top 5% of companies assessed worldwide.
How does that apply to Sysmex UK?
We monitor our energy use and waste generation monthly, reporting this to Sysmex Corporation.
Since 2024, Sysmex UK offices electricity supply is 100% renewable, backed by REGO (Renewable Energy Guarantee of Origin), ensuring that it is generated by renewable sources such as wind, solar, and hydropower, and verified by the Carbon Trust.
On top of this, we have solar panels on our logistics building, generating approximately 18,000 kWh of electricity on site each year.
We work with our waste contractors to ensure that all waste collected from Sysmex premises is disposed of in accordance with the waste hierarchy and have avoided disposal to landfill for over two years.
At Sysmex UK and Ireland we have carried out training in sustainability for all employees, encouraging consideration of sustainability in all business areas. We’ve made several changes to processes to make improvements, which may seems small on their own, but add up to continual improvements in our environmental impact.
Engineer car boot stock is now individual, based on parts usage by individual engineer, removing redundant parts suggested in standard car boot stock formats
Promoting installation of RU-20 units to allow use of concentrated reagents, reducing transport weight and frequency of orders, reducing transport emissions
Increased online training and webinar recordings, reducing trainer and customer travel emissions
Encouraging standing orders for customers and reducing ad hoc deliveries
Introduction of virtual site surveys for suitable projects
Increased use of teams’ meetings to reduce employee and customer travel
Trialling the use of cardboard pallets
The Digital Cell System database management
The CellaVision® digital morphology solutions incorporate robust database management features to help laboratories securely store, organise, and manage case data. Whether operating on a standalone instrument or within a networked environment using CellaVision® Server Software, these tools ensure that laboratories can maintain optimal system performance, manage storage capacity effectively, and comply with data retention requirements.
Effective database management is essential for maintaining system performance and ensuring that valuable morphology data remains accessible and organised. CellaVision® provides intuitive tools and configurable settings that allow laboratories to:
■ Optimise storage capacity by controlling how long smear data is retained.
■ Implement standardised data retention policies in line with local governance or accreditation requirements.
■ Safeguard smear data in multi site networks through secure centralised storage.
■ Ensure continued system responsiveness by preventing database overgrowth.
For laboratories using CellaVision® as a standalone system, a comprehensive suite of database management tools is available directly on the analyser. Storage limits can be configured to set a maximum allowable database size, helping
maintain optimal system performance. Smear data can be managed automatically or manually — with scheduling options that allow older smears to be archived or deleted in accordance with the laboratory’s retention policy, and manual deletion options available for individual or multiple cases. Built-in search and filtering tools allow users to quickly locate specific smears using parameters such as patient ID, date, or type. For long-term storage or audit purposes, smears can also be exported securely to external media via the local backup feature.
In networked environments using CellaVision® Server Software, database management is centralised, enabling more streamlined and scalable storage solutions. All smears captured by connected instruments are stored in a single, secure repository, making them accessible from any authorised review station across the network. Automatic synchronisation ensures that all instruments and users see real-time updates to smear status and classification changes. This shared access model eliminates the need for manual file transfers and supports multi-site collaboration. Server-based systems also offer remote database administration, allowing laboratory managers to configure retention settings, manage archiving schedules, and control user access centrally through the server console.
Best practice for effective database management:
■ Define clear retention policies – Establish how long peripheral blood or body fluid smears should be kept locally before archiving if storing for longer term.
■ Schedule regular maintenance – Configure database settings to align with the laboratory’s storage capacity and data retention policy. Sysmex UK offers a support tool to assist in calculating appropriate limits. Settings can define when to archive or delete smears, where archived data is stored, and when unsigned slides should be automatically removed.
■ Use centralised storage in networked environments –When using CellaVision® Server Software, configure all instruments to automatically save smears to the server database to streamline access and reduce local storage demands.
■ Implement secure backups – Maintain off system backups of important cases for training, quality assurance, or audit purposes.
■ Monitor database size – Keep track of current usage to avoid unplanned downtime or system slow downs. If there is an increase in smear numbers, there needs to be an adjustment of the database retention rules.
The CellaVision® database management tools and settings give laboratories complete control over their morphology case storage, whether working on a standalone system or as part of a networked environment with CellaVision® Server Software. By applying best practice database management, laboratories can ensure optimal system performance, maintain compliance with data retention policies, and preserve valuable morphological data for clinical, educational, and quality purposes.

If any customers want support with the database settings to ensure there are no issues with their database size and performance, please get in touch via ICS_Department@sysmex.co.uk
International Journal of Laboratory Hematology

Sysmex Cell Population Data for Diagnosing Infection in Patients with Suspected Sepsis in the Emergency Department
International Journal of Laboratory Hematology
Volume 48, Issue1, February 2026, Pages 71-80
A group from Oslo University hospital investigated the diagnostic accuracy for infection of white cell population (CP) parameters from Sysmex XN instruments in patients with suspected sepsis in the emergency department (ED). Development and validation cohorts consisted of 600 and 656 patients, respectively made up of adults admitted for possible sepsis and assessed by a “medical rapid response team” or a “sepsis rapid response team”. In addition to Sysmex CP variables, the analysis included C-reactive protein (CRP) and clinical variables were also collected. Sequential organ failure assessment (SOFA) were determined in the ED and blood cultures were taken. Several variables demonstrated moderate (AUC 0.70–0.80) univariate diagnostic accuracy for infection when used individually, particularly MO-X (the complexity of monocytes) and NEUT-RI (reactivity of neutrophils). The optimal multivariable model for infection including MO-X, MO-Z, NEUT-RI and NE-FSC, reached an AUC of 0.86 in the development cohort and an AUC of 0.78 in the validation cohort. MO-X and MO-Z reflects increased activation and size of monocytes, while NEUT-RI and NE-FSC reflect increased activation and size of neutrophils. The group concluded that there is potential value of using CP data in diagnosing infection and suggest further research could explore their relationship to immune responses assayed by other methods. For instance, the association between low monocyte expression of Human Leukocyte Antigen DR isotype (HLA-DR) and immunosuppression in sepsis. The article finishes by hypothesizing that CP variables on the Sysmex analysers may represent a cheap and available proxy for monocyte HLA-DR.
Click here to view the article
05/01/26 10:41 AM

Establishing Reference Ranges and Evaluating Clinical Factors of the Complete Blood Count in Neonates Admitted to a Neonatal Intensive Care Unit
International Journal of Laboratory Hematology
Volume 48, Issue1, February 2026, Pages 81-92
This study aimed to establish updated CBC reference intervals for neonates admitted to the Neonatal Intensive Care Unit (NICU) at the John Radcliffe Hospital in Oxford, while evaluating the effects of these factors on the CBC. Reference intervals for 48 neonatal CBC parameters on the Sysmex XN-450 system were calculated, highlighting the influence of sex, postnatal age, gestational age at birth and corticosteroid exposure. During the study period, 3490 CBC results were collected from 587 neonates, with 386 results from 196 neonates meeting the inclusion criteria. Exclusion criteria included clinical or laboratory indicators suggesting infection or clinical deterioration such as suspicion of maternal or neonatal infection at birth (if within the first 3 days of life); blood, respiratory or cerebrospinal fluid microbiology culture requested, regardless of the result (±5 days); surgical intervention or partial/full blood transfusion (+2 days); suspicion of necrotising enterocolitis (±2 days); viral PCR requested, regardless of the result (± two days); C-reactive protein measurement > 10 mg/L (±1 day); lactate measurement > 4 mmol/L (±1 day); admission of antibiotics or corticosteroids on the same day; three or more signs of clinical deterioration on the same day (tachycardia, tachypnoea, step up in ventilation method, > 10% increase in oxygen requirement, > 1 unit increase in flow or mean airway pressure, temperature instability without therapeutic cooling or hypotension). Sex had a statistically significant effect on only eight parameters, but none exceeded the threshold for clinical relevance. In contrast, postnatal age significantly influenced 31 parameters, with 20 showing clinically relevant effect sizes. RBC and reticulocyte counts remained unaffected. Gestational age at birth significantly impacted 33 parameters, 16 of which demonstrated large effect sizes including increased nucleated RBC and monocyte counts in more preterm neonates. Consistent with adult studies, corticosteroids increased neutrophil counts and decreased lymphocyte counts. However, unlike in adults, corticosteroids did not affect overall RBC counts. Instead, reductions were observed in nucleated RBC and reticulocyte counts.
Click here to view the article

For more information about any of the articles included in this newsletter or to share your thoughts with us, please contact: marketing@sysmex.co.uk
Sysmex Connect Editorial Team
Sysmex UK Essential Contact Details

Main Reception: 0333 320 3460
Product Support
Haematology Team haem.support@sysmex.co.uk
Haemostasis Team coag.support@sysmex.co.uk
IT Team it.support@sysmex.co.uk
Urinalysis Team urine.support@sysmex.co.uk
3D HISTECH Team cellpath.support@sysmex.co.uk
Reagent Ordering reagents@sysmex.co.uk
Flow Cytometry Team flowcytometry.support@sysmex.co.uk
Caresphere Academy
Training Academy Team academy.training@sysmex.co.uk
Technical Support
North Service Hotline: 0333 320 3475 north.service@sysmex.co.uk
South Service Hotline: 0333 320 3476 south.service@sysmex.co.uk
Scotland Service Hotline: 0333 320 3474 scotland.service@sysmex.co.uk
Ireland Service Hotline: 1800 936 590 ireland.service@sysmex.co.uk
Customer Support Centre
Product Application Hotline 0333 320 3466
Poch-100i Hotline 0333 320 3463
MSC Hotline 0333 320 3464
Reagents Hotline 0333 320 3470
Irish Reagent & Consumable Ordering 01 428 7898 sysmexorders@durbinireland.ie

Caresphere Academy
